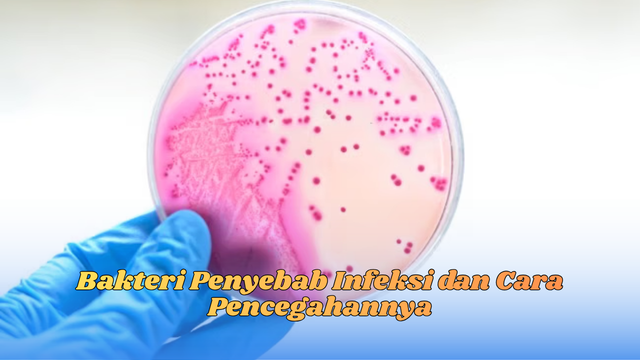
bakteri penyebab infeksi

Pelayanan Terintegrasi untuk Berbagai Kebutuhan Medis
surjitsuperspecialityhospital.com merupakan salah satu rumah sakit rujukan yang menghadirkan layanan medis terintegrasi dengan standar profesional. Rumah sakit ini dibangun dengan konsep super speciality, di mana setiap bidang kesehatan ditangani langsung oleh dokter spesialis. Hal ini memastikan bahwa pasien mendapatkan perawatan yang tepat, cepat, dan sesuai dengan kondisi medis mereka.
Sejak awal kedatangan pasien, proses pemeriksaan dilakukan secara detail. Tim medis menekankan pentingnya evaluasi awal yang akurat agar pengobatan dapat dilakukan secara efektif. Pendekatan yang terstruktur ini membantu pasien merasa lebih nyaman sekaligus meningkatkan keberhasilan perawatan.
Fasilitas Diagnostik Canggih untuk Hasil Pemeriksaan Akurat
Untuk mendukung kualitas diagnosa, Surjit Singh Super Speciality Hospital dilengkapi dengan berbagai fasilitas diagnostik canggih seperti radiologi digital, USG modern, serta laboratorium lengkap. Teknologi ini berfungsi memberikan hasil pemeriksaan yang lebih akurat dan cepat, sehingga dokter dapat segera menentukan langkah penanganan terbaik.
Selain itu, rumah sakit juga menyediakan ruang rawat inap dengan fasilitas lengkap. Kamar rawat dirancang agar pasien dapat menjalani proses pemulihan dengan aman dan nyaman. Kebersihan, pencahayaan, serta ventilasi ruangan menjadi prioritas utama karena berpengaruh besar terhadap kondisi fisik dan mental pasien selama perawatan.
Layanan Emergency 24 Jam dengan Respon Cepat
Dalam kondisi darurat, Surjit Singh Super Speciality Hospital menyediakan tim emergency yang siap beroperasi selama 24 jam penuh. Setiap petugas dilatih untuk menangani situasi kritis secara cepat dan efisien. Ruang gawat darurat dilengkapi peralatan penting seperti ventilator, monitor pasien, serta peralatan medis darurat lainnya untuk memastikan penanganan yang optimal.
Layanan ambulance modern juga disediakan untuk membantu pasien yang membutuhkan transportasi medis cepat dan aman. Dengan kombinasi fasilitas emergency lengkap dan tenaga medis profesional, rumah sakit ini mampu memberikan respon cepat dalam situasi yang membutuhkan tindakan segera.
Kesimpulan
Surjit Singh Super Speciality Hospital menjadi salah satu rumah sakit modern yang mengutamakan kualitas perawatan, keselamatan pasien, dan pelayanan ramah. Dengan dukungan teknologi diagnostik terbaru, ruang rawat inap nyaman, serta layanan darurat 24 jam, rumah sakit ini terus dipercaya sebagai pusat kesehatan yang dapat memenuhi berbagai kebutuhan medis. Profesionalisme dan komitmen tinggi menjadikan Surjit Singh Super Speciality Hospital sebagai pilihan tepat bagi siapa pun yang mencari perawatan berkualitas.